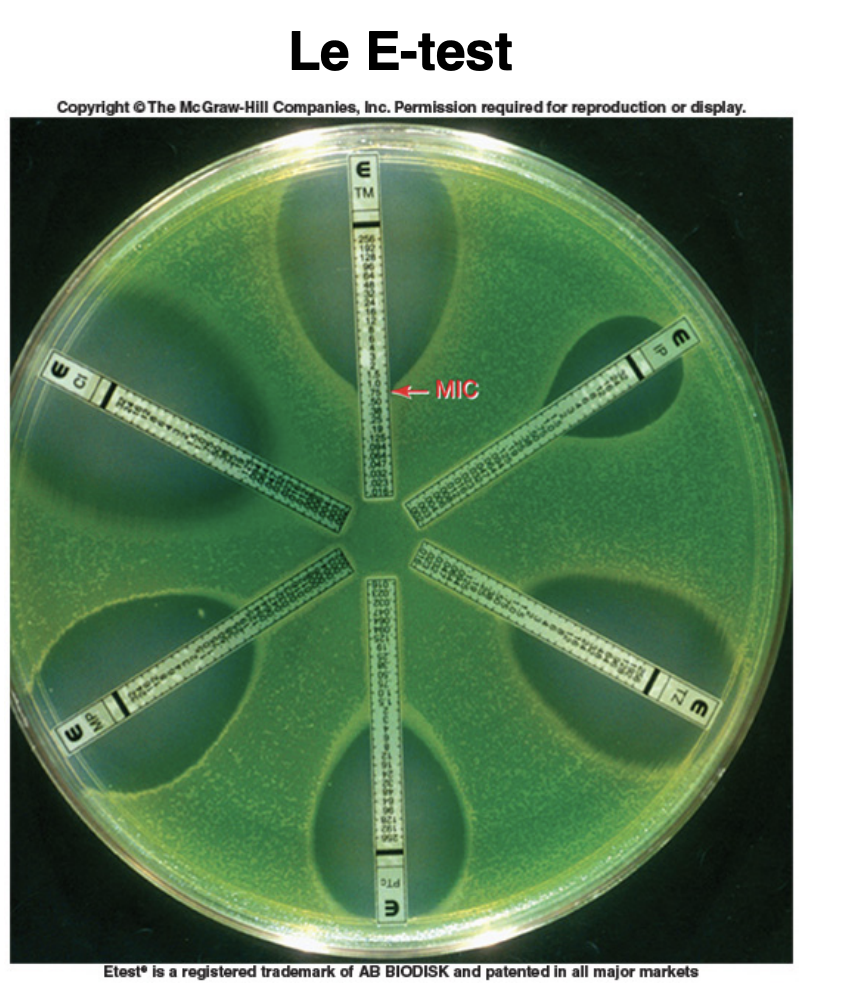

Pourquoi est-il difficile de tuer un microorganisme dans un hote?
Car nous voulons réussir à tuer seulement le microorganismes en ayant le moins d’effet secondaire sur l’hote : la plupart des produits tuent les 2.
Comment fait-on pour arriver à cible seulement le microorganisme sans tuer L,hote?
Ex.?
Tirer profit de la diversité des microorgansimes et fabriquer des molécules spécifique qui cibleront l’envahisseur sans affecter l’hote.
Ex. antibiotique cible paroi peptidoglycan des bactéries
Quest ce que la chimiothérapie?
Traitement des maladies qui utilise agent chimique
QUest ce quun antibiotique?
Agent chimiothérapeutique de faible poid moléculaire capable de tuer la croissance des microorganismes : fonctionne a faible concentraiton pour
QUe découvre Ehrlich?
Que découvre Domagk?
Que découvre Flemming?
QUe découvre Waksman?
Quel sont les 4 types d’antimicrobiens?
De ou proviennent les antibiotique?
Comment calcule t-on l’indice thérapeutique d’un antibiotique?
Indice = dose toxique (élevé) / dose thérapeutique (faible)
Quest ce qu’un spectre d’action? 2 Types?
Spectre : efficacité, qté d’espèces attaqués par un agent
2 types de nature de l’activité microbienne?
Dépend de concentration et espèce microbienne
2 types de concentration minimale?
Pour être efficace, l’antibio doit atteindre qu’elle concentration?
Une concentration supérieur à CMI. Cependant, dans cas des maladies graves (mortelle), il faut très bien controler cette concentration d’agent chimiothérapeutique
Comment déterminer CMI ou CML?

Quest ce qu’un antibiogramme? Méthode?
Déterminer efficacité d’un antibio pour un microorganisme
Méthode Kirby Bauer (diffusion sur gélose):

Est-il possible d’évaluer l’efficacité de 2 antibios différents en mesurant leur diamètre d’inhibition pour 1 espèce?
Non, car vitesse de diffusion et solubilité peut etre différente
Quest ce que le E-test?
Antiobio avec diamètre inhibition comme antibiogramme mais nous montre aussi la CMI.
Quels sont les 3 facteurs qui influencent l’activité des antibios?
Que nous dit cette image?

Antibio classé selon ce qu’ils affectent
5 différents modes d’action des antibios?
Substance qui inhibent paroi? Indice thérapeutique
Indice thérapeutique élevé
Substances qui inhibent synthèse protéine? Indice?
Indide thérapeutique relativement élevé
